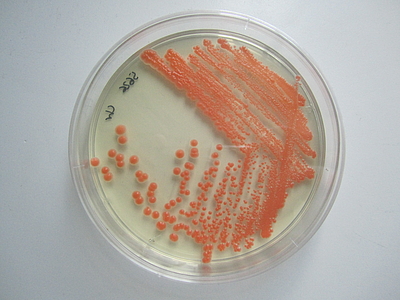

Ingenieurskunst aus Mittweida preisgekrönt beim 99€-Bioreaktorwettbewerb
Am 18ten Mai war es soweit – die erwartete Mail zum Wettbewerb um den besten 99€-Bioreaktor ging in Mittweida ein. Diesmal war das Thema die Fed-batch Kultivierung von Xanthophyllomyces dendrorhous und die Erzeugung des rötlichen Farbstoffes Astaxanthin. Dieser ist recht teuer und findet unter anderem in der Lachszucht als Futtermittelzusatz Verwendung.
Mit Silke Groß und Vivien Wieczorek fanden sich sehr schnell zwei engagierte Studentinnen die trotz anstehender Prüfungen am Projekt arbeiteten. Viel Zeit war nicht – Wettbewerbstage waren bereits der 14/15te Juli. So wurde konstruiert, gebaut und getestet und so manche kleinere und größere Klippe umschifft. Großer Dank gilt hier der Fachgruppe Biotechnologie und Chemie (Nadine Wappler, Eric Zuchantke, Sandra Feik, René Kretschmer), die die Reaktorbauer bei jedweden Problemen und Fragen immer gern unterstützte.
Für das Mittweidaer Team standen dabei moderne Entwicklungen, die gerne hinter Schlagworten wie ‚Internet der Dinge (IoT)‘, ‚Industrie 4.0‘ sowie ‚Do-it-yourself biology (DIY bio)‘ bzw. ‚Biohacking‘ versteckt werden, im Vordergrund. Den Baustart bildeten ein Bonbonglas und ein paar alte Latten vom Sperrmüll. Das Resultat war die „Pink Candy Jar 4.0“; ein wassergekühlter, doppelwandiger Airlift-Reaktor, Steuerung wahlweise via Raspberry Pi oder Arduino, Möglichkeit zur Internetanbindung, diverse Sensoren und Regelsysteme. Aufgrund gewisser technischer (keine Netzwerkanbindung am Wettbewerbsplatz) und finanzieller Beschränkungen (99€!) wurden Boni wie Display am Platz, Sensor für Optische Dichte, und real-time Monitoring und Steuerung über das Internet dann für den Wettbewerb wieder explementiert. Und dann, am 15ten Juli, war es so weit. Nach zeitiger Anreise, Aufbau und Überwindung des starken Wasserdrucks aus der Dresdner Laborwasserleitung erfolgte für das Team pünktlich um 16 Uhr der Startschuss – die Inokulation – wie auch für die Konkurrenten der TU Dresden, HTW Dresden, Fraunhofer CBP und HS Anhalt. Preiskategorien waren die maximale Adsorption bei Wellenlänge 480 nm, der technisch innovativste und der originellste Bioreaktor.
Die Ingenieurskunst aus Mittweida überlebte die Nacht als einer von zwei Reaktoren und gewann schließlich in der Kategorie „Originellstes Reaktordesign“ und das Team um Robert Leidenfrost sammelte 200 Euro Preisgeld ein: Fachgruppen-Grillfest incoming ;-).
Zum Abschluss wurde beim traditionellen Sommerfest der Bioverfahrenstechnik der TU Dresden noch bis spät in die Nacht gefachsimpelt, das Kesselgulasch (bitte „scharf“) und ein möglicherweise gehopftes Kaltgetränk auf Gerstengrundlage genossen. Und so freut sich die HS Mittweida auf das nächste Jahr, wenn es wieder heißt: „Wettbewerb um den besten 99€ - Bioreaktor“.